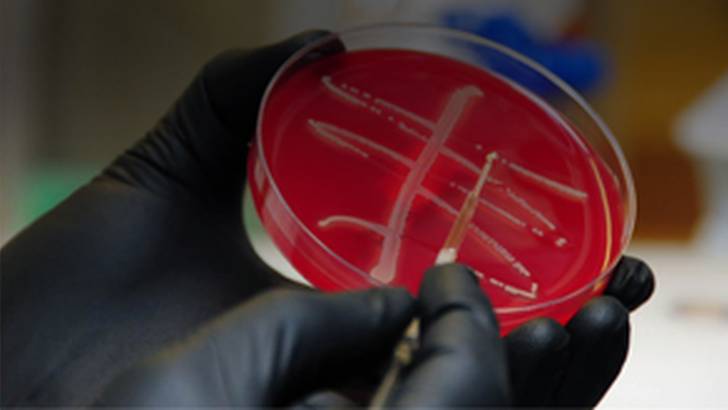
ReachMD Healthcare Image

The Centers for Disease Control and Prevention reported an alarming case in Pennsylvania of a 49-year-old woman who suffered a strain of E.coli causing a urinary tract infection that did not respond to Colistin, an antibiotic of last resort for particularly dangerous superbugs. Dr. Brian McDonough describes the case further.
advertisement
CDC Reports American Case of Colistin-Resistant Superbug
Share
Save
Restart
Resume
Share this program on:
Choose a format
Completing the pre-test is required to access this content.
Completing the pre-survey is required to view this content.
Ready to Claim Your Credits?
You have attempts to pass this post-test. Take your time and review carefully before submitting.
Good luck!
Details
Presenters
Recommended
Details
Presenters
Overview
The Centers for Disease Control and Prevention reported an alarming case in Pennsylvania of a 49-year-old woman who suffered a strain of E.coli causing a urinary tract infection that did not respond to Colistin, an antibiotic of last resort for particularly dangerous superbugs. Dr. Brian McDonough describes the case further.
Title
Share on ReachMD
CloseProgram Chapters
Segment Chapters
Playlist:
advertisement
Recommended
Register
We’re glad to see you’re enjoying ReachMD…
but how about a more personalized experience?
